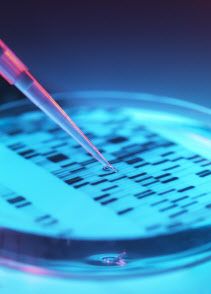

보건복지부는 첨단재생의료 및 첨단바이오의약품 안전 및 지원에 관한 법률 개정에 따라 이같은 제도 시행에 들어간다고 19일 밝혔다.
첨단재생의료는 손상된 인체 세포나 조직·장기 등을 줄기세포, 유전자, 조직공학 치료 등을 통해 대체·재생해 정상기능으로 회복시키는 혁신적인 의료기술이다. 기존 의약품으로 치료가 어려운 중대·희귀·난치 질환을 치료하는 새로운 기회를 제공할 수 있어 전 세계적으로 주목받고 있는 분야다.
|
첨단재생바이오법은 첨단재생의료와 첨단바이오의약품을 안전하게 지원하고 관리하기 위한 내용으로 2020년 시행됐다. 개정안은 임상 연구를 통해 안전성이 확인된 재생의료는 대체치료제가 없는 중대·희귀·난치질환자에 한해 치료를 진행하고 진료비를 청구할 수 있도록 했다. 기업들이 재생의료를 통해 일부 수익을 창출할 수 있다. 다만 무분별한 재생의료 치료 확산을 막기 위해 심의위원회 심의 절차를 두는 등 안전장치도 넣었다.
이에따라 첨단재생의료 치료를 실시하고자 하는 의료기관은 사전에 인체세포등 보관실, 처치실 등 시설·장비와 실시책임자, 담당자 확보 등 인력 요건을 갖춰 복지부 장관의 지정을 받아야 한다. 재생의료기관으로 지정된 후에는 실시하고자 하는 치료의 목적, 대상, 안전성·유효성에 대한 근거, 비용산정 근거 등의 자료를 심의위원회에 제출해 치료 계획의 적합 여부를 심의받아야 한다. 치료계획이 적합 심의를 받으면 계획서에 따른 기간 동안 치료를 실시할 수 있게 된다. 이때 재생의료기관은 심의받은 치료 계획 준수, 이상반응 발생 시 조치방안 마련 및 준수, 치료대상자 건강상태 확인 등 실시기준을 준수해야 한다.
신꽃시계 복지부 첨단의료지원관은 “첨단재생의료 치료제도를 통해 그간 국내에서 세포치료 등을 받지 못한 환자들에게 새로운 치료기회를 제공할 수 있을 것으로 기대한다”며 “첨단재생의료를 이용하는 환자들이 안전하게 치료받을 수 있도록 심사 및 관리체계를 정비하고 강화해 나가겠다”라고 강조했다.
Copyright ⓒ 이데일리 무단 전재 및 재배포 금지
본 콘텐츠는 뉴스픽 파트너스에서 공유된 콘텐츠입니다.